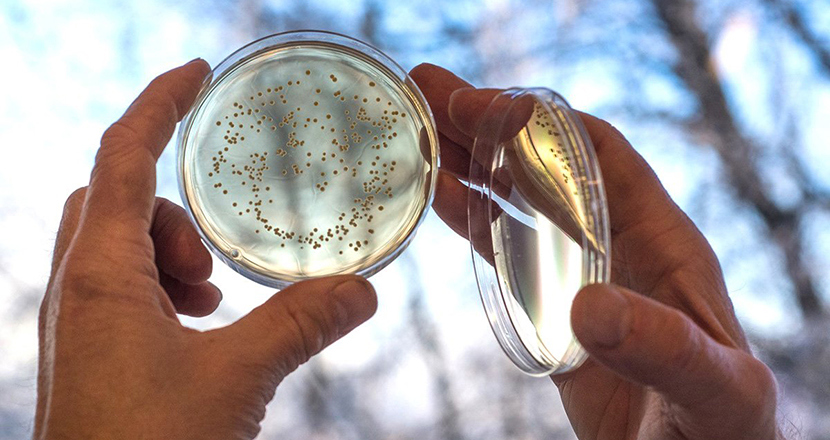

Mjölksyrabakterier kan skynda på läkning av sår
[ Forskning ] Det finns idag bara två godkända läkemedel med dokumenterad effekt. För att kunna ta fram fler har forskare vid Uppsala universitet under flera års tid utvecklat en teknik som bygger på att mjölksyrabakterier producerar så kallat terapeutiskt protein direkt i såren.
[ Läs mer ] på Forskning.se